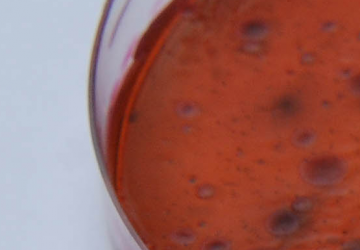

WHY CHOOSE FMV?
There are many variations of passages of Lorem Ipsum available, but the majority have suffered alteration in some form, by injected humour, or randomised words which don't look even slightly believable. If you are going to use a passage of Lorem Ipsum, you need to be sure there isn't anything embarrassing hidden in the middle of text amr songr balga ami toami valo lasi ciri din akr dali
Learn NowOur Departments
Our four didactic departaments
Important facts
Some relevant facts of our activity
Teachers
79%
Members
120+
Courses
36%
Graduates
2000+
Latest News
There are many variations of passages
OUR EVENTS
There are many variations of passages
Re-evaluarea EAEVE 5-7 Aprilie
În perioada 5-7 Aprilie, Facultatea de Medicină Veterinară Cluj-Anpoca a continuat procedura de evaluarea EAEVE
Learn NowVizita delegatiei OIE si
Martial Petitclerc, Inspecteur Général des services vétérinaires détaché auprès de l’OIE M.Faugère, Directeur de l’Ecole
Learn Now